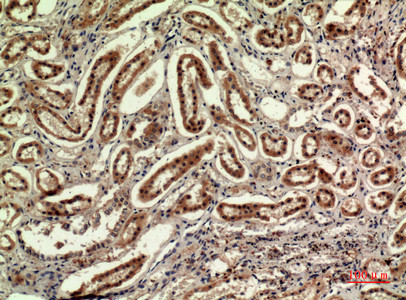
Immunohistochemical analysis of paraffin-embedded human-kidney, antibody was diluted at 1:100

Anti-IDH1 antibody (N-Term) (STJ96781)
SPECIFICATIONS
ClonalityPolyclonal
HostRabbit
ConjugationUnconjugated
IsotypeIgG
ImmunogenSynthesized peptide derived from the N-terminal region of human IDH1.
General Information
| Short Description | Rabbit polyclonal anti-Isocitrate dehydrogenase cytoplasmic-specific ICDH (N-Term) for use in WB, IHC, IF and ELISA in Human, Mouse and Rat samples. Datasheet included with dilution recommendations, and related reagents. |
| Applications | WB/IHC/IF/ELISA |
| Host | Rabbit |
| Reactivity | Human/Mouse/Rat |
| Note | STRICTLY FOR FURTHER SCIENTIFIC RESEARCH USE ONLY (RUO). MUST NOT TO BE USED IN DIAGNOSTIC OR THERAPEUTIC APPLICATIONS. |
Product Properties
| Clonality | Polyclonal |
| Isotype | IgG |
| Conjugation | Unconjugated |
| Concentration | 1 mg/mL |
| Purification | The antibody was affinity-purified from rabbit antiserum by affinity-chromatography using epitope-specific immunogen. |
| Dilution Range | WB 1:500-1:2000IHC-P 1:100-1:300ELISA 1:20000IF 1:50-200 |
| Formulation | Liquid in PBS containing 50% Glycerol, 0.5% BSA and 0.02% Sodium Azide. |
| Storage Instruction | Store at-20°C for up to 1 year from the date of receipt, and avoid repeat freeze-thaw cycles. |
Target Information
| Gene Symbol | IDH1 |
| Gene ID | 3417 |
| Uniprot ID | IDHC_HUMAN |
| Immunogen | Synthesized peptide derived from the N-terminal region of human IDH1. |
| Immunogen Region | N-Term |
| Specificity | IDH1 Polyclonal Antibody detects endogenous levels of IDH1 protein. |
Additional Info
| Function | Catalyzes the NADP(+)-dependent oxidative decarboxylation of isocitrate (D-threo-isocitrate) to 2-ketoglutarate (2-oxoglutarate), which is required by other enzymes such as the phytanoyl-CoA dioxygenase. Plays a critical role in the generation of NADPH, an important cofactor in many biosynthesis pathways. May act as a corneal epithelial crystallin and may be involved in maintaining corneal epithelial transparency. |
| Protein Name | Isocitrate Dehydrogenase Nadp CytoplasmicIdhIdh1Cytosolic Nadp-Isocitrate DehydrogenaseIdpcNadp(+-Specific IcdhOxalosuccinate Decarboxylase |
| Database Links | Reactome: R-HSA-2978092Reactome: R-HSA-389542Reactome: R-HSA-6798695Reactome: R-HSA-9033241Reactome: R-HSA-9818025 |
| Cellular Localisation | CytoplasmCytosolPeroxisome |
| Alternative Antibody Names | Anti-Isocitrate Dehydrogenase Nadp Cytoplasmic antibodyAnti-Idh antibodyAnti-Idh1 antibodyAnti-Cytosolic Nadp-Isocitrate Dehydrogenase antibodyAnti-Idpc antibodyAnti-Nadp(+-Specific Icdh antibodyAnti-Oxalosuccinate Decarboxylase antibodyAnti-IDH1 antibodyAnti-PICD antibody |
Information sourced from Uniprot.org